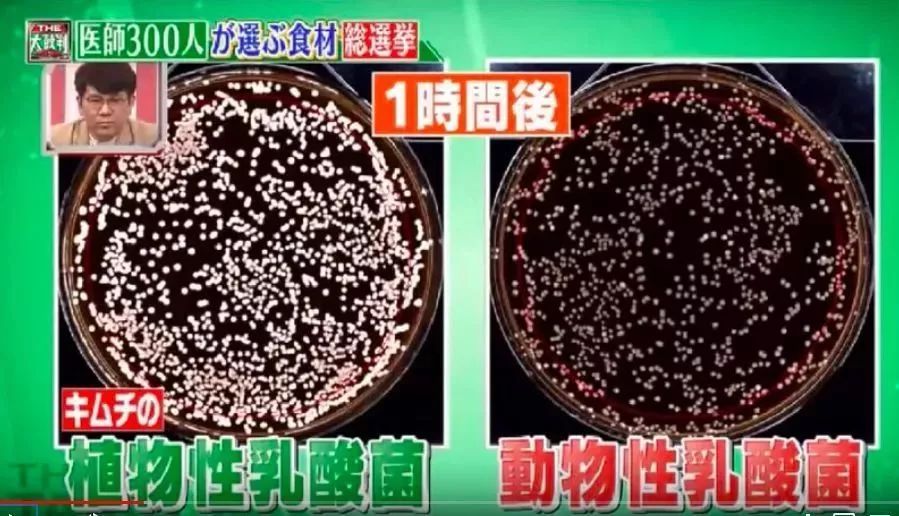

本文转自日式生活美学(ID:fangxuehou2015)
要说世界上最长寿的国家
那一定非日本莫属
在世界卫生组织最新发表的
《2019年世界卫生统计年鉴》中
日本依然是排在首位的国家
继续蝉联冠军,而中国排在了53名


据调查显示
日本的人均寿命要比中国高10年
日本的百岁老人人数也在不断创新高
连续32年持续增长
在吉斯尼世界记录的官网上
目前全球最长寿的老人(116岁)
就来自日本

老人健康长寿,年轻劳动力又短缺
导致很多60、70岁的老人们
还奋斗在社会岗位上
不得不让人感叹日本的晚年生活
和我们的晚年生活
还是有不少区别的......

身体是革命的本钱
无论是安度晚年还是投入工作
拥有一个健康的身体都是前提
“病从口入”、“健康都是吃出来的”
“饮食习惯非常重要”......
在中国的主流观念里
健康离不开“吃”
那么,日本人这么长寿
是不是和吃也有很大关系呢?
日本节目就请了300位名医投票
选出了最有利于健康的10种食材
还公布了食材背后不为人知的特效

但是上榜的食材
一定会让你意想不到
第十名:苹果

“一天一个苹果,医生远离我”
这句话大家都听过,上榜并不意外
苹果的好处相信不用我多说
补充维生素、增强身体抵抗力等等都是常识

但是,日本现在对苹果有了新的研究发现
他们发现苹果可以改善肺炎
帮助肺部恢复活力


为了验证这一说法
节目组做了两组实验:

实验1:
日本青森县是苹果生产大省,节目组专访青森县的苹果农户,在医生的协助测试下,发现农户们的肺年龄比实际年龄都要低很多,一问才知道他们基本上每周都吃好几个苹果。
实验2:
节目组邀请了女嘉宾线下参与实验,这位嘉宾26年每天吸烟20支,导致肺部年龄远超实际年龄,在节目组的督促下坚持每天吃一个苹果。

坚持了三周之后
她的肺部年龄竟然从74岁变成61岁!

此外,加热苹果还可以增加果胶
有望在防止血管老化方面发挥作用
然后节目组就端出了一盘苹果农户们
自创的新吃法:“苹果馅炸饺子”

这个奇怪的饺子馅,让我不禁想起了日本的珍珠饺子......
第九名:泡菜
这个就很出乎意料了有木有?
泡菜属于腌制品,在中国的饮食理念中
腌制品和健康很难联系在一起
甚至可能会上危害健康的食品榜
怎么日本就把它评选成十大健康食品了呢?
原来
日本医生认为泡菜富含植物乳酸菌
1克的泡菜里面就富含1000万个乳酸菌
通过它可以有效改善肠道环境

而且泡菜比一般的咸菜含盐量低
可以有效控制摄盐量

为了验证自己的说法
节目组又开始做实验了:
节目组请实验室将乳酸菌
放入人工胃液中培养
3小时后检查数量,发现动物乳酸菌几乎消失
但植物乳酸菌基本保持不变

可以得出结论
植物乳酸菌能一直跑到肠胃,促进肠道蠕动循环
第八名:牛油果
牛油果可是近几年的新宠食材
牛油果沙拉、牛油果寿司、牛油果意大利面......
因为营养价值高而备受追捧
可除了大家熟知的保护肝脏
美容养颜等功效外
牛油果竟然还能改善膝盖疼痛!

根据医生的说法
牛油果具有修复受损软骨的作用
其中的大豆不皂化物可以补充软骨

节目组放出了两组图
左边是不吃牛油果的膝盖
右边是吃牛油果的膝盖
很明显右边的软骨部分要比左边厚一点
看来牛油果的功效,真的比想象中更多啊!
第七名:番茄

番茄美容养颜抗氧化的功能众所周知
可除了让我们更年轻更好看外
番茄中的番茄红素还可以预防动脉硬化
分解血凝块并预防脑梗塞等
那么,怎么烹饪才能更好地吸收它的营养呢?

节目组给出的答案是加热吃!
西红柿的番茄红素很容易通过加热吸收到体内
加热吃比常温冷吃的营养高出三倍以上
医生还指出
最好在加热煮时倒点食用油
营养会更容易吸收
第六名:西兰花
西兰花含有丰富的维生素、
矿物质和膳食纤维,被称为蔬菜之王
因为维生素C能溶于水
所以医生建议煮着吃比较能保存营养
直接微波炉加热是最没有营养的吃法

而你一定想不到的是
西兰花竟然可以预防白发、脱发!
这是因为西兰花菜牙中的萝卜硫素有抗氧化作用
所以可以有效改善白发和脱发

节目组邀请了三位女士线下测试
连续吃两周西兰花菜芽之后
三位女士的头皮血液循环都有了很大改善

只听说黑色食品对可以乌发防止脱发
没想到西兰花竟然也有这个功效......
第五名:醋

常听人说吃醋会对身体好
可到底好在哪你知道吗?
据数据调查,日本境内最爱食用醋的就是完治的故乡
——愛媛県

巧的是,厚生劳动省显示的高龄者比重排行榜里
愛媛県位列第八名,是个长寿之地!

原来,醋可以抑制血糖升高和血压
恢复疲劳,并提高新陈代谢。
更神奇的是,醋还可以与鸡蛋搭配吃
效果奇佳,含钙量高,能让你的骨头更坚硬!



据节目组介绍
这个吃法在愛媛県很流行
从德川时代开始流行至今

醋与钙在一起吸收能增加1.2倍吸收率
因此多吃醋也有利于骨头的生长
有效解决了老年人骨质疏松的问题呢!
第四名:豆腐

豆腐作为日常食材
在各种菜里都能见到
它不仅富含植物蛋白、可预防动脉硬化、
降低胆固醇,还能减脂肪!

节目组提到了长野县的特有食物:长野粉豆腐
在长野县,家家户户做菜都会倒一点粉豆腐作为调味料


节目组又请了一个嘉宾线下测试。
在连续吃了三周粉豆腐之后,脂肪下去了
人也瘦了,看起来精神十足!

看来豆腐的营养价值比我们想象中更高啊!
第三名:酸奶
(酸奶有纯素做法,普通酸奶只适合蛋奶素者)

酸奶一直广受消费者的喜爱,不仅口感好
还能改善肠道环境,营养又健康
但是怎样吃酸奶才能把酸奶的营养发挥到极致呢?
首先这里要解开一个食用误区
超市里卖的酸奶一盒买回来打开
很多都已经沉淀了,有人会把浮出来的水倒掉

但其实倒掉是最亏的
因为乳清里含有大量营养
每天食用200克~300克酸奶有助于消化
避免便秘问题

大家可以在酸奶中添加干果或是坚果
或者添加柿饼等等,坚持下来会发现皮肤变好哦!
第二名:青鱼
第一名:纳豆
纳豆不仅带一点臭味,还会有点苦
需要较重的调料才能压住异味

日本有吃纳豆的习惯
但是中国人却很少会接受这个食物
但是纳豆的营养价值非常高,富含丰富的蛋白质
能控制血糖含量,预防三高
还能预防便秘
纳豆的食用方法有很多
医生说有些做法会对纳豆原本的营养造成损失
建议避开:
1.放在热腾腾的饭上

2.搅拌次数过多

以上就是日本300位名医投票选出的
最利于健康的10大食材了
大都是我们日常生活中随处可见、
随处可买的素食食材

饮食习惯非常重要,
要想身体健康,
看来是时候要改变了~
